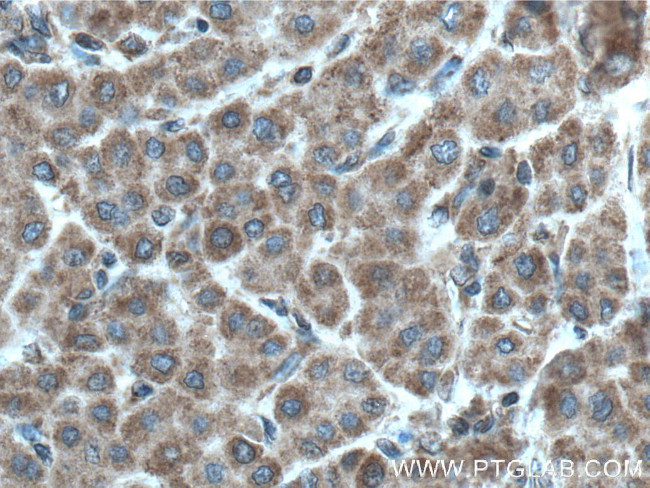
PDSS2 Antibody in Immunohistochemistry (Paraffin) (IHC (P))

Search
Proteintech
PDSS2 Polyclonal Antibody
{{$productOrderCtrl.translations['antibody.pdp.commerceCard.promotion.promotions']}}
{{$productOrderCtrl.translations['antibody.pdp.commerceCard.promotion.viewpromo']}}
{{$productOrderCtrl.translations['antibody.pdp.commerceCard.promotion.promocode']}}: {{promo.promoCode}} {{promo.promoTitle}} {{promo.promoDescription}}. {{$productOrderCtrl.translations['antibody.pdp.commerceCard.promotion.learnmore']}}








Please note: We are reviewing Western blot images included in the antibody testing data in our catalog, including those provided by third parties. Unless expressly labeled or annotated as “raw-unedited”, Western blot images included in the antibody testing data in our catalog may have been edited, optimized or otherwise adjusted for presentation.
产品信息
13544-1-AP
种属反应
已发表种属
宿主/亚型
分类
类型
抗原
偶联物
形式
浓度
规格
纯化类型
保存液
内含物
保存条件
运输条件
产品详细信息
PDSS2 has 2 isoforms with MW of 44 kDa and 27 kDa while 13544-1-AP antibody detects the bands around 27-30 kDa and 44-47 kDa in SDS-PAGE.
Immunogen sequence: MNFRQLLLH LPRYLGASGS PRRLWWSPSL DTISSVGSWR GRSSKSPAHW NQVVSEAEKI VGYPTSFMSL RCLLSDELSN IAMQVRKLVG TQHPLLTTAR GLVHDSWNSL QLRGLVVLLI SKAAGPSSVN TSCQNYDMVS GIYSCQRSLA EITELIHIAL LVHRGIVNLN ELQSSDGPLK DMQFGNKIAI LSGDFLLANA CNGLALLQNT KVVELLASAL MDLVQGVYHE NSTSKESYIT DDI (1-242 aa encoded by BC039906)
靶标信息
The isoprenoid chain of ubiquinone (coenzyme Q) varies in length between species and is determined by trans-polyprenyl diphosphate synthase. Humans possess a heterotetrameric decaprenyl diphosphate synthase composed of DPS1 and DLP1 (PDSS2) that produces Q10 ubiquinone.The isoprenoid chain of ubiquinone (coenzyme Q) varies in length between species and is determined by trans-polyprenyl diphosphate synthase. Humans possess a heterotetrameric decaprenyl diphosphate synthase composed of DPS1 and DLP1 (PDSS2) that produces Q10 ubiquinone.
仅用于科研。不用于诊断过程。未经明确授权不得转售。
生物信息学
蛋白别名: All trans-polyprenyl-diphosphate synthase PDSS2; All-trans-decaprenyl-diphosphate synthase subunit 2; decaprenyl pyrophosphate synthase subunit 2; decaprenyl pyrophosphate synthetase subunit 2; Decaprenyl-diphosphate synthase subunit 2; prenyl (solanesyl) diphosphate synthase, subunit 2; prenyltransferase-like mitochondrial protein; RP11-59I9.3; Solanesyl-diphosphate synthase subunit 2
基因别名: 5430420P03Rik; Dlp1; Gm60; kd; mDLP1; Pdss2; Plmp
UniProt ID: (Rat) Q5U2R1, (Mouse) Q33DR3
Entrez Gene ID: (Rat) 365592, (Mouse) 71365